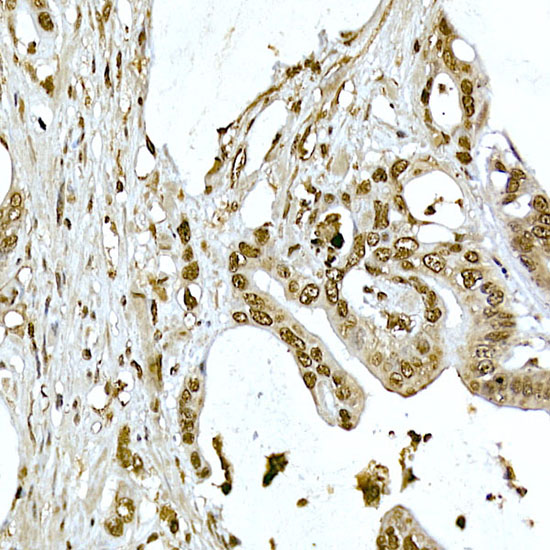
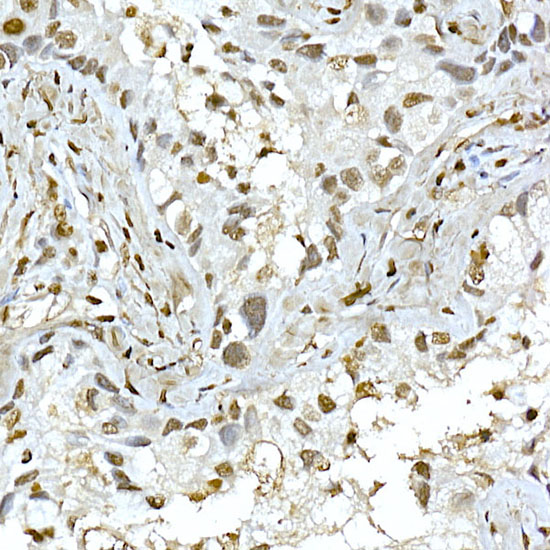

Anti-AKT1 Antibody
A80442
ApplicationsImmunoFluorescence, ImmunoPrecipitation, Western Blot, ImmunoCytoChemistry, ImmunoHistoChemistry
Product group Antibodies
ReactivityHuman, Mouse, Rat
Overview
- SupplierAntibodies.com
- Product NameAnti-AKT1 Antibody
- Delivery Days Customer7
- ApplicationsImmunoFluorescence, ImmunoPrecipitation, Western Blot, ImmunoCytoChemistry, ImmunoHistoChemistry
- CertificationResearch Use Only
- ClonalityPolyclonal
- ConjugateUnconjugated
- HostRabbit
- IsotypeIgG
- Scientific DescriptionRabbit polyclonal antibody to AKT1.
- ReactivityHuman, Mouse, Rat
- UNSPSC12352203

![IHC-P analysis of human prostate carcinoma section using GTX02583 AKT1 antibody [rAKT1/2491].](https://www.genetex.com/upload/website/prouct_img/normal/GTX02583/GTX02583_20210319_IHC-P_1_w_23053122_113.webp)

